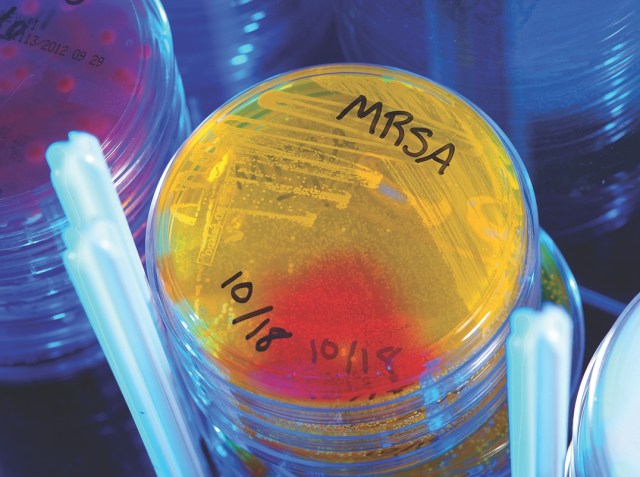

Eradication treatment aims to remove Staph. aureus (MRSA or MSSA) and reduce your risk from recurrent skin infection. If the first eradication treatment is unsuccessful, repeat treatment may be required. MRSA= methicillin-resistant Staphylococcus aureus (commonly referred to as golden staph); MSSA = methicillin-susceptible Staphylococcus aureus
Natural history of recurrent staphylococcal infection Types of Staphylococcus aureus (including MRSA) can cause recurrent skin infections (e.g. boils) in children and adults who are otherwise well. The infections may recur over many months. Eventually the episodes become less frequent or disappear as the body (immune system) learns to deal with them. That may take […]

Our JMO pre-test survey also asked “What puzzles you about antibiotics and their use”. A recurring theme was concern about remembering the various classes and names of antibiotics. Here are some useful pointers and a short quiz !
Question 3 of our JMO pre-test survey asked about the aims of antimicrobial stewardship (yes, better ‘antimicrobial’ than ‘antibiotic’- antiviral, antifungal, antiparasitic resistance are issues as well). We gave you three options and all except one responded with the correct answer – all three! The order is important – treatment of the individual patient comes first: Optimise the effectiveness […]
Q2 in our JMO pre-test asked: “What is the main mechanism by which the bacterium Staphylococcus aureus becomes resistant to penicillin?” We gave alternatives enumerating basic mechanisms that micro-organisms use (often in combination) to become resistant to an antimicrobial agent (graphic below). Production of penicillinase (i.e. inactivation by a type of beta-lactamase) was the correct answer– more […]
The antibiotic knowledge survey of our new interns this week, showed that many were confused about which class vancomycin (a glycopeptide) fell into (30% thought it was an aminoglycoside). This is a potentially dangerous confusion as the dosing, side effects and monitoring all differ substantially between these classes: Aminoglycoside Glycopeptide Indicative agents Gentamicin Vancomycin Dosing […]

Guest posting from Dr Hema Varadhan, Clinical Microbiologist, Pathology North. This parasite intrigues me every time I validate a faecal PCR result. Why do we see these bugs more often than the others? Do we care? Do we need to treat? The RCPA recently provided relevant guidance concerning Blastocystis and Dientamoeba which is also useful […]

In 2015 NPS MedicineWise partnered with Tropfest, to launch a short film competition to raise awareness about antibiotic resistance. Here are our picks of the 15 finalists– definitely worth a revisit! First prize – “The Pick Up” of the not-so lovely Ms Gonorrhoea! “Antibiotic man” “Pills“ The #savethescript judging panel included: Dr Andrew Rochford, Seven Network Health Editor […]

What does AIMED stand for? https://aimed.net.au/about . Kearney standing proud at the Antibiotic Awareness Week displays at Calvary Mater Hospital this week:
Pathology stewardship – an essential element of AMS
Poor antimicrobial prescribing decisions often are triggered by laboratory results that create red herrings or worse. Inappropriate/ poor specimen collection and/or a request form that provides no context to the investigation often sets the ball rolling. Inappropriate workup and reporting of contaminant or colonising isolates may then follow (it may be impossible for the lab […]